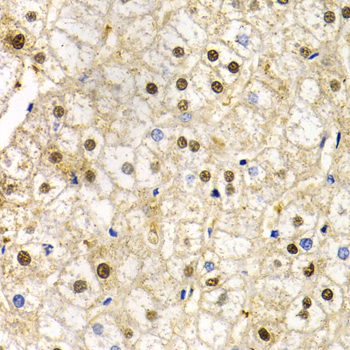

For quotations, please use our online quotation form, and you may also contact us by
service@kendallscientific.com
+1-888.733.6849 (Toll-free)
+1-617.299.7367 (Int’l))
+1-888.733.6849
Our customer service representatives are available 24 hours, Monday through Friday to assist you.| Reactivity | Human Mouse Rat |
| Tested applications | WB IHC IF |
| Recommended Dilution | WB 1:500 - 1:2000 IHC 1:50 - 1:200 IF 1:50 - 1:200 |
| Calculated MW | 42kDa |
| Observed MW | Refer to Figures |
| Immunogen | Recombinant protein of human RAD9A |
| Storage Buffer | Store at -20℃. Avoid freeze / thaw cycles. Buffer: PBS with 0.02% sodium azide, 50% glycerol, pH7.3. |
| Concentration | be |
| Synonym | RAD9; |

Western blot analysis of extracts of mouse heart cells, using RAD9A antibody.

Immunohistochemistry of paraffin-embedded rat liver using RAD9A antibody at dilution of 1:200 (400x lens).
Immunohistochemistry of paraffin-embedded human liver damage using RAD9A antibody at dilution of 1:200 (400x lens).

Immunofluorescence analysis of MCF7 cell using RAD9A antibody. Blue: DAPI for nuclear staining.

Immunofluorescence analysis of U2OS cell using RAD9A antibody. Green:BRCA1 used for DNA damage marker. Blue: DAPI for nuclear staining. Cells were treated by UV-A laser.

Immunofluorescence analysis of U2OS cell using RAD9A antibody. Green:BRCA1 used for DNA damage marker. Blue: DAPI for nuclear staining. Cells were treated by UV-A laser.
This gene product is highly similar to Schizosaccharomyces pombe rad9, a cell cycle checkpoint protein required for cell cycle arrest and DNA damage repair. This protein possesses 3' to 5' exonuclease activity, which may contribute to its role in sensing and repairing DNA damage. It forms a checkpoint protein complex with RAD1 and HUS1. This complex is recruited by checkpoint protein RAD17 to the sites of DNA damage, which is thought to be important for triggering the checkpoint-signaling cascade. Alternatively spliced transcript variants encoding different isoforms have been found for this gene. [provided by RefSeq, Aug 2011]
N/A